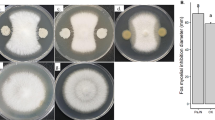

Abstract
There are increasing efforts to identify biocontrol-active microbial metabolites in order to improve strategies for biocontrol of phytopathogens. In this work, Fusarium oxysporum f. sp. conglutinans was confronted with three different biocontrol agents: Trichoderma harzianum, Bacillus amyloliquefaciens, and Pseudomonas aeruginosa in dual culture bioassays. Metabolites produced during the microbial interactions were screened by a matrix-assisted laser desorption/ionization mass spectrometry (MALDI-MS). T. harzianum exhibited the strongest inhibition of growth of F. oxysporum resulting in overlay of the pathogen colony with its mycelium. Recorded metabolite profiles suggested a direct attack of F. oxysporum mycelium by T. harzianum and B. amyloliquefaciens by means of membrane-attacking peptaibols and a set of antimicrobial lipopeptides and siderophores, respectively. The direct mode of the biocontrol activity of T. harzianum and B. amyloliquefaciens corresponded to their ability to suppress F. oxysporum production of mycotoxin beauvericin suggesting that this ability is not specific only for Trichoderma species. In the case of P. aeruginosa, siderophores pyoverdine E/D and two rhamnolipids were produced as major bacterial metabolites; the rhamnolipid production was blocked by F. oxysporum. The results showed that this type of biocontrol activity was the least effective against F. oxysporum. The effective application of MALDI-MS profiling to the screening of nonvolatile microbial metabolites produced during the interaction of the phytopathogen and the biocontrol microorganisms was demonstrated.
Similar content being viewed by others
Avoid common mistakes on your manuscript.
Introduction
The biological control of fungal phytopathogens by microbes is a widely studied strategy. However, the mechanisms through which antagonistic microorganisms affect pathogens are often not clear. Members of Fusarium oxysporum species complex are typically ubiquitous soil-borne pathogens that cause vascular wilt and root rot in a wide range of plants and are considered among top 10 fungal pathogens in molecular plant pathology based on the scientific and economic importance (Dean et al. 2012; Aoki et al. 2014). F. oxysporum f. sp. conglutinans (Foc) causes fusarium wilt of cabbage that is responsible for significant economic losses (Li et al. 2015a; Liu et al. 2017).
Bacterial lipopeptides, fungal sesquiterpenoids, and volatile terpenes have been recognized to play important roles in microbial interactions and biological control (Romero et al. 2007; Malmierca et al. 2016; Schmidt et al. 2016). Pyrrolnitrin and pyoverdine were demonstrated to participate in pseudomonas biocontrol activities (Paulitz and Loper 1991; Ligon et al. 2000). B. amyloliquefaciens produced surfactin, iturin, and fengycin in the interaction zone with the pathogen Macrophomina phaseolina (Torres et al. 2016). In Trichoderma species, a variety of biocontrol-active metabolites was described (Liu et al. 2016; Mutawila et al. 2016; Pascale et al. 2017), including an active production of siderophores (Angel et al. 2016).
Modern metabolomic analyses offer better means for identification of broad profiles of metabolites compared to previous approaches. They have been used to decipher the host resistance mechanisms against fungal pathogens (e.g., Gunnaiah and Kushalappa 2014; Dhokane et al. 2016; Li et al. 2017). This work focused on profiling microbial metabolites produced during growth of the fungal pathogen F. oxysporum f. sp. conglutinans race 2 with three biocontrol agents (BCAs), P. aeruginosa, B. amyloliquefaciens, and T. harzianum, in dual cultures on the agar medium using matrix-assisted laser desorption/ionization mass spectrometry (MALDI-MS). The Foc race 2 strain was used because of its much higher pathogenicity compared to race 1 (Li et al. 2015b). The microbes were grown in dual cultures on agar media and metabolites present in the Foc-BCA interaction zones were analyzed.
Materials and methods
Microorganisms
Fusarium oxysporum f. sp. conglutinans race 2 strain (Foc) was obtained from the Isolate Collection of Naktuinbouw (Roelofarendsveen, The Netherlands) and Trichoderma harzianum CCF2714 from the Culture Collection of Fungi (Charles University, Prague, Czech Republic). Fungal strains were maintained on potato dextrose agar (PDA, Oxoid Ltd., UK–potato extract 4 g/L, dextrose 20 g/L, agar 15 g/L, pH 5.6) and stored at 4 °C. Bacillus amyloliquefaciens DSM23117 was obtained from DSMZ–German Collection of Microorganisms and Cell Cultures (Germany) and Pseudomonas aeruginosa ATCC 15692 from American Type Culture Collection (USA). Bacteria were stored in a Luria-Bertani medium (LB; consisting of tryptone 10 g/L, yeast extract 5 g/L, NaCl 10 g/L, pH 7.0) containing 30% glycerol at − 80 °C.
Instruments and chemicals
MALDI-MS experiments were performed on a 12T SolariX FTICR (Fourier transform ion cyclotron resonance) mass spectrometer (Bruker Daltonics, Billerica, MA, USA). Full-scan MS data were acquired in a mass range 40–3000 m/z with an external calibration on a mixture of peptides (Pepmix II, Bruker Daltonics, Germany) and clusters of matrices with a mass accuracy better than 5 ppm. Samples (2 μL) were spotted on MALDI plate, dried, and covered with either α-cyano-4-hydroxycinnamic acid (CHCA) [2 μL of CHCA, 10 mg/mL in 50% acetonitrile (ACN)─0.1% trifluoroacetic acid] or 2,5-dihydroxybenzoic acid (2 μL of DHB, 10 mg/mL in 50% ACN─0.1% trifluoroacetic acid) matrix. Instrument parameters were optimized and desorption of the samples was performed with SmartBeam II laser (laser power 30%, 200 scans, 2 kHz). MALDI matrices were obtained from Bruker Daltonics (Germany). The high-purity solvents used for MALDI-MS analysis were obtained from Sigma-Aldrich (USA) and Merck (Germany).
Dual culture assays
Fungal strains were inoculated with a mycelial plug (7 mm in diameter) cut from a stock culture and the bacteria with an amount of 3 × 107 bacterial cells (volume 10 μL) grown overnight in the liquid LB medium at 30 °C and 160 rpm. All cultures were incubated at 28 °C for 10 days. The experiments were conducted in triplicates.
Metabolic profiling
For metabolomic studies, the dual cultures and individual strains were grown on the Bushnel-Haas agar medium (BH; consisting of magnesium sulfate 0.2 g/L, calcium chloride 0.02 g/L, potassium hydrogenphosphate 1 g/L, potassium dihydrogenphosphate 1 g/L, ammonium nitrate 1 g/L, ferric chloride 0.05 g/L, glucose 5 g/L, and agar 20 g/L, pH 7.0). Fe3+ ions were thus a component of all metabolomic studies. The metabolites produced by the microorganisms were determined after a 5-day cultivation, and the samples were taken from control cultures of the individual microbes and from the interaction zones of dual cultures. To determine the metabolites, samples of 1 g of BH agar from the individual strain cultures and the interaction zones of dual cultures were cut and homogenized by pressing through a syringe. The homogenized agar was centrifuged at 16000g for 10 min. The supernatants were transferred into clean tubes and stored at − 80 °C.
MALDI-MS and MS/MS spectra were acquired in positive-ion mode in the range of 150–3000 Da. The spectrum of fusaric acid was acquired in the range of 40–1500 Da. Samples were mixed with matrix (CHCA or DHB) in 1:1 ratio, the mixture was spotted on a MALDI plate, and the mass spectra were collected. The mass spectra were searched using CycloBranch software (Novák et al. 2015, 2017) against in-house metabolite databases designed for all studied BCAs. The isolated ions were further subjected to analysis by tandem mass spectrometry (MS/MS) and the resulting spectra were compared to the spectra in a public GNPS Library [http://gnps.ucsd.edu/, spectra no. CCMSLIB00000846455 (fusaric acid), CCMSLIB00003739997 (bacillibactin), CCMSLIB00000006851 (3-O-(α-L-rhamnopyranosyl-(1–2)-α-L-rhamnopyranosyl)-3-hydroxydecanoyl-3-hydroxydecanoic acid), CCMSLIB00003142432 (beauvericin)] or compared to “in silico” generated MS/MS spectra of the corresponding metabolites by CycloBranch. The minimum threshold of relative intensity and m/z error tolerance were 1% and 5 ppm, respectively.
Results and discussion
Dual culture assays on PDA medium
In dual cultures with Foc T. harzianum was able to inhibit the growth of Foc starting from day 2 of cultivation on PDA medium (Fig. 1). In later stages, T. harzianum overlaid the Foc colony with its mycelium and a red metabolite appeared beneath the colony (Fig. 1b). Production of red and purple polyketide and naphthoquinonic pigments by soil-borne phytopathogenic strain of F. oxysporum have been described, the former having antifungal properties (Limon et al. 2010; Lebeau et al. 2018). Both bacterial strains exhibited a partial inhibition of Foc growth with a clear inhibition zone of 2–5 mm formed between Foc and B. amyloliquefaciens (Fig. 1).
Growth of Fusarium oxysporum f. sp. conglutinans (Foc zb1) in co-cultivation with biocontrol agents on PDA medium. Figures of 10-day old cultures: a control culture of Foc; b Foc-T. harzianum dual culture; c Foc-B. amyloliquefaciens dual culture; d Foc-P. aeruginosa dual culture; e Foc colony diameter after 10-day growth
The differences in Foc inhibition by individual BCA could be attributed to different biocontrol mechanisms. Trichoderma species are known to influence mycelial growth of Fusarium species in dual culture bioassays on PDA medium (Blaszczyk et al. 2017; Sharma et al. 2017). T. harzianum T-soybean has been recently shown to inhibit growth of Foc by parasitic function (Zhang et al. 2017). B. amyloliquefaciens is supposed to inhibit pathogenic fungi due to fungicidal effects of its lipopeptides as demonstrated in dual cultures with Macrophomina phaseolina (Torres et al. 2016), while in the case of pseudomonads, the biocontrol activity towards Foc was connected with the production of siderophore pseudobactin B10 (Kloepper et al. 1980).
Metabolic profiling
In order to analyze microbial metabolites, the cultures were grown on mineral BH medium to avoid the interference of complex media constituents with the analyses. In this experiment, the inhibition measured in dual cultures was similar to that recorded on PDA (data not shown), except that no red colored metabolite was visible in Foc-T. harzianum co-cultures. The metabolites identified in the control cultures of individual microbes are shown in Table 1. MS/MS spectra of the individual compounds are reported in Online Resource (Figs. S2-S11).
In single Foc cultures, a limited number of metabolites were detected. Unlike F. oxysporum strain FGSC9935 that has recently been reported to produce three different ferrichrome siderophores (Lopez-Berges et al. 2012), ferricrocin was the only detected siderophore in Foc cultures in this work. Ferricrocin was also the only siderophore measured in T. harzianum control cultures although up to 15 siderophores were reported to be produced by this fungus (Lehner et al. 2013). Those observations can probably be explained by the presence of Fe3+ ions in the medium during metabolomic studies. Further, the mycotoxin beauvericin was detected in MALDI-MS spectra of Foc cultures. As no enniatins were found, the Foc strain probably belongs to Fusarium species with a beauvericin-producing profile (Liuzzi et al. 2017). Production of fusaric acid was also recorded in Foc cultures (Table 1). This toxin is responsible for phytotoxic effects of Foc on tomato plants (Singh et al. 2017) and may help the fungus compete with other microbes in soil (Martin-Rodriguez et al. 2014; Quecine et al. 2016).
In the control cultures of P. aeruginosa (Table 1), the siderophores pyoverdine E/D were produced that could help compete with the siderophore activity of fusaric acid produced by Foc (cf. Ruiz et al. 2015). The bacterium also produced rhamnolipids that are known to exhibit antifungal effects (Reddy et al. 2016; DaSilva Araujo et al. 2017).
In the control cultures of B. amyloliquefaciens, fengycin A and bacillomycin D1 and D2 were detected (Table 1). Three molecules of fengycin A with different lengths of C chains were found. Fengycin and iturin lipopeptides as well as bacillomycins D1/D2 are known to have antifungal activities (Caldeira et al. 2011; Gu et al. 2017) and are involved in competitive interactions with other microorganisms (e.g., Torres et al. 2016; Ben Ayed et al. 2017). Bacillibactin, a trilacton-based natural siderophore, was also found in the B. amyloliquefaciens monocultures (Table 1). Lipopeptide and siderophore profiles of B. amyloliquefaciens detected were in accordance with the reports of B. amyloliquefaciens SQR9 that was shown to fine-tune its lipopeptide and bacillibactin production to control different fungal pathogens (Li et al. 2014) (Table 2).
In the control cultures of T. harzianum, besides the siderophore ferricrocin mentioned above (Table 1), peptaibols were also detected and their MALDI-MS spectrum is shown in Online Resource (Fig. S1). The presence of 11-, 14-, and 18-residue series of these peptides (Table 3) was confirmed on the basis of the precise mass measurement and a simulation of the molecular formula of each isobaric group of peptides (Mukherjee et al. 2011). Detection of these membrane-attacking, antibiotic peptides suggested a parasitic mode of action of T. harzianum in the antagonistic interactions and corroborated the hypothesis that Trichoderma species attack phytopathogens by destroying fungal cell walls by a synergistic action of lytic enzymes and antibiotic metabolites (Benitez et al. 2004).
The metabolites detected in co-cultures of Foc and BCAs are summarized in Tables 2 and 4 to show their changes occurring during the antagonistic interactions in these cultures suggesting possible mechanisms involved. Generally, the antagonist interactions involved were operating at two different levels. The first level was that of the iron available in the environment as reflected by the changes in the production of compounds involved in the sequestration of iron. The co-cultivation with both bacteria resulted in disappearance of the production of the intracellular siderophore ferricrocin by Foc that was found to be involved in intracellular iron storage in aspergilli and whose deficiency resulted in a reduced virulence of A. fumigatus and Magnaporthae grisaea (Hof et al. 2007; Wallner et al. 2009). On the other hand, the production of fusaric acid by Foc also exhibiting the iron sequestration activity (Ruiz et al. 2015) was maintained in co-cultures with both bacteria as well as the productions of siderophores pyoverdine E/D by P. aeruginosa and bacillibactin by B. amyloliquefaciens (Table 4) and these compounds could thus be involved in mutual competitions. The effect of the iron sequestration in the antagonistic interaction of T. harzianum and Foc was difficult to evaluate as the siderophore ferricrocin was produced by both fungi and, in addition, Foc maintained the production of fusaric acid (Tables 2 and 4).
The other level of the antagonist interactions included the production of specific compounds with antifungal and antibacterial activities. Here, a clear difference between the two bacteria was observed. B. amyloliquefaciens was able to maintain the production of bacillomycins and fengycin A, compounds shown to exhibit antifungal activities, in the presence of Foc and, at the same time, blocked the production of beauvericin by Foc, a compound having an antibacterial effect. It suggested that this bacterium was effective in the mycotoxin suppression similar to Trichoderma species (Blaszszyk et al. 2017). In contrast, in the case of P. aeruginosa, the production of bacterial rhamnolipids having an antifungal effect was blocked in the presence of Foc and the synthesis of beauvericin by Foc was maintained (Table 2). Such inhibition of rhamnolipid production in P. aeruginosa was reported to be mediated by microbial quorum quenching compounds (Rajesh and Rai 2016). The difference between the two bacteria may explain a higher inhibition of Foc growth by B. amyloliquefaciens (Fig. 1). In the co-culture with Foc, T. harzianum maintained the production of peptaibols exhibiting an antifungal and fungicidal activity and blocked the production of beauvericin by Foc, which resulted in a strong inhibition of Foc growth (Table 2, Fig. 1) The production of fusaric acid by Foc was present in all co-cultures with both the bacteria and T. harzianum suggesting that this compound with the antibacterial and antifungal activities (Son et al. 2008) was involved in the antagonistic interactions observed.
No new compounds were detected in the monocultures of the microorganisms used (compared to studies in the literature; Pathma et al. 2011); similarly, any new product was not found in the dual cultures studied. However, by comparing the antagonistic interactions of Foc with various prokaryotic and eukaryotic microorganisms, the study enabled us to observe a general pattern of response of Foc at the metabolomic level to the exposure to antagonists.
Conclusions
Fungal pathogen F. oxysporum f. sp. conglutinans race 2 (Foc) was confronted with three biological control agents of different efficiency. The observed inhibitory effect on Foc growth was in the order T. harzianum > B. amyloliquefaciens > P. aeruginosa. Two types of biocontrol effects were observed in bacterial and fungal antagonisms, a competition for iron mediated by siderophores and direct antibiotic effect(s) mediated by various antagonist metabolites. The efficient biocontrol activities of T. harzianum and B. amyloliquefaciens resulted from the membrane-attacking effects of peptaibols in the case of T. harzianum and the antifungal activity of the combination of bacillomycins and fengycin in the case of B. amyloliquefaciens. Simultaneously, both antagonists were also able to suppress the production of antibacterial antibiotic beauvericin by Foc. The results demonstrate that Fusarium wilt agent can be efficiently suppressed by biocontrol organisms offering thus a bioalternative to the treatment of crops by chemical pesticides.
References
Angel LPL, Yusof MT, Ismail IS, Ping BTY, Azni INAM, Kamarudin NHJ, Sundram S (2016) An in vitro study of the antifungal activity of Trichoderma virens 7b and a profile of its non-polar antifungal components released against Ganoderma boninense. J Microbiol 54:732–744. https://doi.org/10.1007/s12275-016-6304-4
Aoki T, O’Donnell K, Geiser DM (2014) Systematics of key phytopathogenic Fusarium species: current status and future challenges. J Gen Plant Pathol 80:189–201. https://doi.org/10.1007/s10327-014-0509-3
Ben Ayed H, Hmidet N, Bechet M, Jacques P, Nasri M (2017) Identification and natural functions of cyclic lipopeptides from Bacillus amyloliquefaciens An6. Eng Life Sci 17:536–544. https://doi.org/10.1002/elsc.201600050
Benitez T, Rincon AM, Limon MC, Codon AC (2004) Biocontrol mechanisms of Trichoderma strains. Int Microbiol 7:249–260 www.im.microbios.org
Blaszszyk L, Basinska-Barczak A, Cwiek-Kupczynska H, Gromadzka K, Popiel D, Stepien L (2017) Suppressive effect of Trichoderma spp. on toxigenic Fusarium species. Pol J Microbiol 66:85–100
Caldeira AT, Santos Arteiro JM, Coelho AV, Roseiro JC (2011) Combined use of LC-ESI-MS and antifungal tests for rapid identification of bioactive lipopeptides produced by Bacillus amyloliquefaciens CCMI1051. Process Biochem 46:1738–1746. https://doi.org/10.1016/j.procbio.2011.05.016
Cezard C, Farvacques N, Sonnet P (2015) Chemistry and biology of pyoverdines, Pseudomonas primary siderophores. Curr Med Chem 22:165–186
DaSilva Araujo FD, Araujo WL, Eberlin MN (2017) Potential of Burkholderia seminalis TC3.4.2R3 as biocontrol agent against Fusarium oxysporum evaluated by mass spectrometry imaging. J Am Soc Mass Spectrom 28:901–907. https://doi.org/10.1007/s13361-017-1610-6
Dean R, Van Kan JA, Pretorius ZA, Hammond-Kosack KE, Di Pietro A, Spanu PD, Rudd JJ, Dickman M, Kahmann R, Ellis J, Foster GD (2012) The top 10 fungal pathogens in molecular plant pathology. Mol Plant Pathol 13:414–430. https://doi.org/10.1111/J.1364-3703.2011.00783.X
Dhokane D, Karre S, Kushsalppa AC, McCartney C (2016) Integrated metabolo-transcriptomics reveals Fusarium head blight candidate resistance genes in wheat QTL-Fhb2. PLoS One 11(5):e0155851. https://doi.org/10.1371/Journal.pone.0155851
Gu Q, Yang Y, Yuan QM, Shi GM, Wu LM, Lou ZY, Huo R, Wu HJ, Borriss R, Gao XW (2017) Bacillomycin D produced by Bacillus amyloliquefaciens is involved in the antagonistic interaction with the plant-pathogenic fungus Fusarium graminearum. Appl Environ Microbiol 83:UNSP e01075–UNSP e01017. https://doi.org/10.1128/AEM.01075-17
Gunnaiah R, Kushalappa AC (2014) Metabolomics deciphers the host resistance mechanisms in wheat cultivar Sumai-3 against trichothecene producing and non-producing isolates of Fusarium graminearum. Plant Physiol Biochem 83:40–50. https://doi.org/10.1016/j.plaphy.2014.07.002
Haba E, Pinazo A, Jauregui O, Espuny MJ, Infante MR, Manresa A (2003) Physicochemical characterization and antimicrobial properties of rhamnolipids produced by Pseudomonas aeruginosa 47T2 NCBIM 40044. Biotechnol Bioeng 81:316–322. https://doi.org/10.1002/bit.10474
Hof C, Eisfeld K, Welzel K, Antelo L, Foster AJ, Anke H (2007) Ferricrocin synthesis in Magnaportae grisaea and its role in pathogenicity in rice. Mol Plant Pathol 8:163–172. https://doi.org/10.1111/J.1364-2007.00380.X
Kloepper JW, Leong J, Teintze T, Schroth MN (1980) Pseudomonas siderophores: a mechanism explaining disease-suppressive soils. Curr Microbiol 4:317–320. https://doi.org/10.1007/BF02602840
Lebeau J, Petit T, Clerc P, Dufosse L, Caro Y (2018) Isolation of two novel purple naphthoquinone pigments concomitant with the bioactive red bikaverin and derivatives thereof produced by Fusarium oxysporum. Biotechnol Prog. https://doi.org/10.1002/btpr.2738
Lehner SM, Atanasova L, Neumann NKN, Krska R, Lemmens M, Druzhinina IS, Schuhmacher R (2013) Isotope-assisted screening for iron-containing metabolites reveals a high degree of diversity among known and unknown siderophores produced by Trichoderma spp. Appl Environ Microbiol 79:18–31. https://doi.org/10.1128/AEM.02339-12
Li B, Li Q, Xu Z, Zhang N, Shen Q, Zhang R (2014) Responses of beneficial Bacillus amyloliquefaciens SQR9 to different soilborne fungal pathogens through the alteration of antifungal compounds production. Front Microbiol 5:636. https://doi.org/10.3389/fmicb.2011.00636
Li E, Wang G, Yang Y, Xiao J, Mao Z, Xie B (2015a) Microscopic nalysis of the compatible and incompatible interactions between Fusarium oxysporum f. sp. conglutinans and cabbage. Eur J Plant Pathol 141:597–609. https://doi.org/10.1007/s10658-014-0567-6
Li E, Ling J, Wang G, Xiao J, Yang Y, Mao Z, Wang X, Xie B (2015b) Comparative proteomics analyses of two races of Fusarium oxysporum f. sp. conglutinans that differ in pathogenicity. Sci Rep-UK 5:13663. https://doi.org/10.1038/srep13663
Li WB, Li CQ, Sun JB, Peng M (2017) Metabolomic, biochemical and gene expression analyses reveal the underlying responses of resistant and susceptible banana species during early infections with Fusarium oxysporum f. sp. cubense. Plant Dis 101:534–543. https://doi.org/10.1094/PDIS-09-16-1245-RE
Ligon JM, Hill SD, Hammer PE, Torkewitz NR, Hofmann D, Kempf HJ, vanPee KH (2000) Natural products with antifungal activity from Pseudomonas biocontrol bacteria. Pest Manag Sci 56:688–695. https://doi.org/10.1002/1526-4998(200008)56:8<688::AID-PS186>3.0.CO;2-V
Limon MC, Rodríguez- Ortiz R, Avalos J (2010) Bikaverin production and applications. Appl Microbiol Biotechnol 87:21–29. https://doi.org/10.1007/s00253-010-2551-1
Liu S-Y, Liao C-K, Lo C-T, Yang H-H, Lin K-C, Peng K-C (2016) Chrysophenol is involved in the biofertilization and biocontrol activities of Trichoderma. Physiol Mol Plant Pathol 96:1–7. https://doi.org/10.1016/j.pmpp.2016.06.003
Liu X, Ling J, Xiao Z, Xie B, Fang Z, Yang L, Zhang Y, Lv H, Yang Y (2017) Characterization of emerging populations of Fusarium oxysporum f. sp. conglutinans causing cabbage wilt in China. J Phytopathol 165:813–821. https://doi.org/10.1111/jph.12621
Liuzzi VC, Mirabelli V, Cimmarusti MT, Haidukowski M, Leslie JF, Logrieco AF, Caliandro R, Fanelli F, Mule G (2017) Enniantin and beauvericin biosynthesis in Fusarium species: production profiles and structural determinant prediction. Toxins 9:45. https://doi.org/10.3390/toxins9020045
Lopez-Berges MS, Capilla J, Turra D, Schafferer L, Matthijs S, Joechl C, Cornelis P, Guarro J, Haas H, DiPietro A (2012) HapX-mediated iron homeostasis is essential for rhizosphere competence and virulence of the soilborne pathogen Fusarium oxysporum. Plant Cell 24:3805–3822. https://doi.org/10.1105/tpc.112.098624
Malmierca MG, Izquirdo-Bueno I, McCormick SP, Cardoza RE, Alexander NJ, Barua J, Lindo L, Casquero PA, Collado IG, Monte E, Gutierrez S (2016) Trichothecenes and aspinolides produced by Trichoderma arundinaceum regulate expression of Botrytis cinerea genes involved in virulence and growth. Environ Microbiol 18:3991–4004. https://doi.org/10.1111/1462-2920.13410
Martin-Rodriguez AJ, Reyes F, Martin J, Perez-Yepez J, Leon-Barrios M, Couttolenc A, Espinoza C, Trigos A, Martin VS, Norte M, Fernandez JJ (2014) Inhibition of bacterial quorum sensing by extracts from aquatic fungi: first report from marine endophytes. Mar Drugs 12:5503–5526. https://doi.org/10.3390/md12115503
Meca G, Sospedra I, Soriano JM, Ritieni A, Moretti A, Manes J (2010) Antibacterial effect of the bioactive compound beauvericin produced by Fusarium proliferatum on solid medium of wheat. Toxicon 6:349–354. https://doi.org/10.1016/j.toxicon.2010.03.022
Mukherjee PK, Wiest A, Ruiz N, Keightley A, Moran-Diez ME, McCluskey K, Pouchus YF, Kenerley CM (2011) Two classes of new peptaibols are synthesized by a single non-ribosomal peptide synthetase of Trichoderma virens. J Biol Chem 286:4544–4554. https://doi.org/10.1074/jbc.M110.159723
Mutawila C, Vinal F, Halleen F, Lorito M, Mostert L (2016) Isolation, production and in vitro effects of the major secondary metabolite produced by Trichoderma species used for the control of grapevine trunk diseases. Plant Pathol 65:104–113. https://doi.org/10.1111/ppa.12385
Novák J, Lemr K, Schug KA, Havlíček V (2015) CycloBranch: De novo sequencing of nonribosomal peptides from accurate product ion mass spectra. J Am Soc Mass Spectrom 26:1780–1786. https://doi.org/10.1007/s13361-015-1211-1
Novák J, Sokolová L, Lemr K, Pluháček T, Palyzová A, Havlíček V (2017) Batch-processing of imaging or liquid-chromatography mass spectrometry datasets and de novo sequencing of polyketide siderophores. Biochim Biophys Acta 1865:768–775. https://doi.org/10.1016/j.bbapap.2016.12.003
Pascale A, Vinale F, Manganiello G, Nigro M, Lanzuise S, Ruocco M, Marra R, Lombardi N, Woo SL, Lorito M (2017) Trichoderma and its secondary metabolites improve yield and quality of grapes. Crop Prot 92:176–181. https://doi.org/10.1016/j.cropro.2016.11.010
Pathma J, Rahul GR, Kennedy RK, Subashri R, Sakthival N (2011) Secondary metabolite production by bacterial antagonists. J Biol Control 25:165–181
Paulitz TC, Loper JE (1991) Lack of a role for fluorescent siderophore production in the biological control of Pythium damping-off of cucumber by a strain of Pseudomonas putida. Phytopathology 81:930–935. https://doi.org/10.1094/Phyto-81-930
Quecine MC, Kidarsa TA, Goebel NC, Shaffer BT, Henkels MD, Zabriskie TM, Loper JE (2016) An interspecies signaling system mediated by fusaric acid has parallel effects on antifungal metabolite production by Pseudomonas protegens strain Pf-5 and antibiosis of Fusarium spp. Appl Environ Microbiol 82:1372–1382. https://doi.org/10.1128/AEM.02574-15
Rajesh PS, Rai VR (2016) Inhibition of QS-regulated virulence factors in Pseudomonas aeruginosa PAO1 and Pectobacterium carotovorum by AHL-lactonase of endophytic bacterium Bacillus cereus VT96. Biocatal Agr Biotechnol 7:154–163. https://doi.org/10.1016/j.bcab.2016.06.003
Reddy KS, Khan MY, Archana K, Reddy MG, Hameeda B (2016) Utilization of mango kernel oil for the rhamnolipid production by Pseudomonas aeruginosa DR1 towards its application as biocontrol agent. Bioresour Technol 221:291–299. https://doi.org/10.1016/j.biortech.2016.09.041
Romero D, deVicente A, Rakotoaly RH, Dufour SE, Veening JW, Arrebola E, Cazorla FM, Kuipers OP, Paquot M, Perez-Garcia A (2007) The iturin and fengycin families of lipopeptides are key factors in antagonism of Bacillus subtilis toward Podospaera fusca. Mol Plant-Microbe Interact 20:430–440. https://doi.org/10.1094/MPMI-20-4-0430
Ruiz JA, Bernar EM, Jung K (2015) Production of siderophores increases resistance to fusaric acid in Pseudomonas protegens Pf-5. PLoS One 10:e0117040. https://doi.org/10.1371/journal.pone.0117040
Schmidt R, Etalo DW, deJager V, Gerards S, Zweers H, deBoer W, Garbeva P (2016) Microbial small talk: volatiles in fungal-bacterial interactions. Front Microbiol 6:1495. https://doi.org/10.3389/fmicb2015.01495
Sharma V, Salwan R, Sharma PN, Kanwar SS (2017) Elucidation of biocontrol mechanisms of Trichoderma harzianum against different plant fungal pathogens: universal yet host specific response. Int J Biol Macromol 95:72–79. https://doi.org/10.1016/j.ijbiomac.2016.11.042
Shi M, Chen L, Wang X-W, Zhang T, Zhao P-B, Song X-Y, Sun C-Y, Chen X-L, Zhou B-C, Zhang Y-Z (2012) Antimicrobial peptaibols from Trichoderma pseudokoningii induce programmed cell death in plant fungal pathogens. Microbiology 158:166–175. https://doi.org/10.1099/mic.0.052670-0
Singh VK, Singh HB, Upadhyay RS (2017) Role of fusaric acid in the development of Fusarium wilt symptoms in tomato: physiological, biochemical and proteomic perspectives. Plant Physiol Biochem 118:320–332. https://doi.org/10.1016/j.plaphy.2017.06.028
Son SW, Kim HY, Choi GJ, Lim HK, Jang KS, Lee SO, Lee S, Sung ND, Kim J-C (2008) Bikaverin and fusaric acid from Fusarium oxysporum show antioomycete activity against Phytophthora infestans. J Appl Microbiol 104:692–698. https://doi.org/10.1111/j.1365-2672.2007.03581.x
Torres MJ, Brandan CP, Petroselli G, Erra-Balsells R, Audisio MC (2016) Antagonistic effects of Bacillus subtilis subsp. subtilis and B. amyloliquefaciens against Macrophomina phaseolina: SEM study of fungal changes and UV-MALDI-TOF MS analysis of their bioactive compounds. Microbiol Res 182:31–39. https://doi.org/10.1016/j.micres.2015.03.005
Tung TT, Jakobsen TH, Dao TT, Fuglsang AT, Givskov M, Christensen SB, Nielsen J (2017) Fusaric acid and analogues as Gram-negative bacterial quorum sensing inhibitors. Eur J Med Chem 126:1011–1020. https://doi.org/10.1016/j.ejmech.2016.11.044
Wallner A, Blatzer M, Schrettl M, Sarg B, Lindner H, Haas H (2009) Ferricrocin, a siderophore involved in intra- and transcellular iron distribution in Aspergillus fumigatus. Appl Environ Microbiol 75:4194–4196. https://doi.org/10.1128/AEM.00479-09
Wang Q, Xu L (2012) Beauvericin, a bioactive compound produced by fungi: a short review. Molecules 17:2367–2377. https://doi.org/10.3390/molecules17032367
Zhang F, Chen C, Zhang F, Gao L, Liu J, Chen L, Fan X, Liu C, Zhang K, He Y, Chen C, Ji X (2017) Trichoderma harzianum containing 1-aminocyclopropane-1-carboxylate deaminase and chitinase improved growth and diminished adverse effect caused by Fusarium oxysporum in soybean. J Plant Physiol 210:84–94. https://doi.org/10.1016/j.jplph.2016.10.012
Funding
The work was supported by QJ1510088 project of Ministry of Agriculture of the Czech Republic and LO1509 and LTC18009 projects of the Ministry of Education, Youth and Sports of the Czech Republic.
Author information
Authors and Affiliations
Corresponding author
Ethics declarations
Conflict of interest
The authors declare that they have no conflict of interest.
Additional information
Publisher’s note
Springer Nature remains neutral with regard to jurisdictional claims in published maps and institutional affiliations.
Electronic supplementary material
ESM 1
(PDF 707 kb)
Rights and permissions
About this article
Cite this article
Palyzová, A., Svobodová, K., Sokolová, L. et al. Metabolic profiling of Fusarium oxysporum f. sp. conglutinans race 2 in dual cultures with biocontrol agents Bacillus amyloliquefaciens, Pseudomonas aeruginosa, and Trichoderma harzianum. Folia Microbiol 64, 779–787 (2019). https://doi.org/10.1007/s12223-019-00690-7
Received:
Accepted:
Published:
Issue Date:
DOI: https://doi.org/10.1007/s12223-019-00690-7